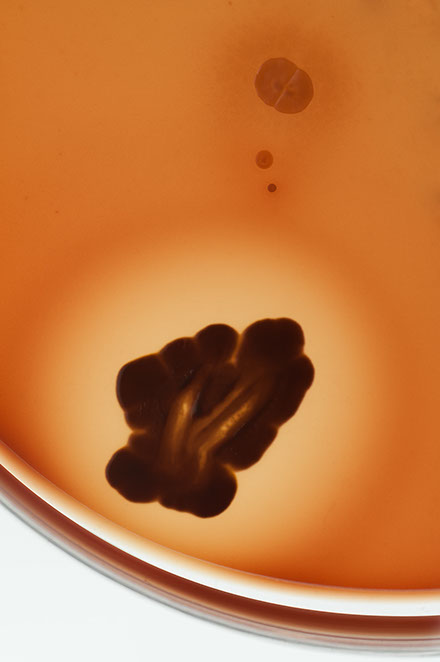

colour













© yon marsh 2017
images are all copyrighted Yon Marsh - no unauthorised use

colour

© yon marsh 2017
images are all copyrighted Yon Marsh - no unauthorised use